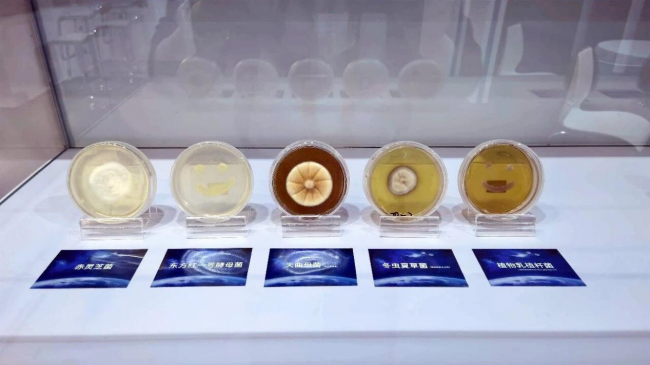

4月24日,2026年“中国航天日”主场活动在四川成都盛大启幕。正值中国航天事业创建70周年,本次活动以“七秩问天路 携手探九霄”为主题,由工业和信息化部、国家航天局、四川省人民政府联合主办,成都市人民政府、四川大学承办。活动现场,航天硬核突破与民生应用成果交相辉映,全方位展现中国航天七十载辉煌征程与科技惠民的时代价值。

重磅成果勾勒航天强国新蓝图
4月24日上午,第十一个中国航天日主场活动迎来多项重磅发布。国家航天局集中发布了嫦娥五号月球样品最新科学成果“镁嫦娥石”和“铈嫦娥石”、天问三号任务合作项目遴选结果、“羲和二号”国际合作机遇公告、商业航天标准体系1.0版等多项航天领域重大信息。
中国航天科技集团有限公司研究员、北斗重大专项工程副总师谢军,中国科学院院士、中国科学院空天信息创新研究院党委书记、副院长张兵,中国人民解放军航天员大队特级航天员叶光富当选2026年度“中国航天公益形象大使”。

现场还颁布了2025年度“中国航天基金会奖”。中国科学院院士杨孟飞获“钱学森最高成就奖”,新型远程飞行器技术创新团队、鹊桥二号中继星任务创新团队、空间站工程总体科技创新团队获“钱学森创新团队奖”,俄罗斯国家航天集团公司萨维利耶夫·谢尔盖获“航天国际合作奖”。

活动期间还发布了我国“十五五”时期将实施的多项重大航天工程。国家航天局局长单忠德表示,未来将加力推进载人航天、月球探测、行星探测、国家卫星互联网等重大工程,并加快论证重型运载火箭、可重复使用火箭及新一代空间基础设施等航天强国工程。
思想碰撞解锁航天医学未来应用图景
作为本次大会的重要分论坛之一,"航天生物医学服务于人类深空健康"专题会汇聚了国内外航天医学领域数十位顶级专家和学术权威,就空间生命科学领域的布局规划、先进理论和技术成果展开深入探讨,为搭建高水平的跨学科、跨机构开放协作平台,培育与发展航天医学新质生产力贡献智慧与力量。

据了解,空间生命科学主要研究地球生物在空间环境下的响应规律,以及宇宙生命起源与演化问题,是人类长期太空探索的核心支撑。论坛致力于汇聚多方力量,推动空间生命科学成果转化,让航天医学更好服务于航天强国建设与大众健康。

论坛期间,空间生物主动健康研究院院长、东方红航天生物副总裁刘静博士,以 “科学构建数智主动健康管理平台——AI技术与精准健康干预融合”为题,详解数智化主动健康管理系统的服务模式与技术优势,阐释航天技术赋能 “评估-预测-干预-随访” 全流程精准化、个性化健康管理的创新路径。

东方红航天生物航天医学应用首席专家谢瑶博士,围绕“模拟中长期太空微重力环境影响的健康防控研究及应用”作专业解读,分享企业融合中医药与生物发酵技术开展空间防护研究的有关情况,阐明项目研究成果对航天员健康保障、中医药与航天医学融合发展的重要价值。
“我们的声音上太空” 搭建“航天梦想之桥”
作为面向全民的国家级航天主题纪念日,今年的航天日活动现场还举办了丰富多样的航天公益科普活动。在第六届“我们的声音上太空”启动仪式上,东方红航天生物向航天科技国际交流中心移交了首批作品,公司执行总裁牛晨出席仪式并获颁交接授权证书。


“我们的声音上太空”活动是在中国科协科普部、国家航天局系统工程司、中国航天科技集团有限公司科技委指导下,由中国航天科技国际交流中心等单位联合主办的大型航天科普公益活动,自2020年创办以来已成功举办五届。活动面向全民征集音视频祝福与心愿,入选作品将通过航天器送入太空,以全民之声致敬航天精神、传递家国情怀。
东方红航天生物多年来积极投身航天公益科普事业。此次参加“我们的声音上太空”活动,希望能够助力构建航天科技与大众文化之间的桥梁,推动“硬核科技”与“人文精神”的深度融合,让航天梦更加深入人心。
航天科普盛宴彰显“硬核与温度”
中国航天日航天科普展示活动于4月24日至5月5日举行,通过模型、实物等展示空间技术、空间科学、空间应用、商业航天以及四川省航天产业成就。
科普成就展区重点围绕70年来中国航天重大历史事件、航天精神、功勋人物等布设,展出嫦娥五号和六号两次任务取回的月球样品、玄武岩国旗等实物,空间站天和核心舱1:1模型、长征五号运载火箭模型等珍贵实物与模型。
航天产业展区汇聚20余家央国企及行业骨干单位,全面展示航天技术研发、装备制造、产业配套等关键环节的最新突破。商业航天展区则聚焦产业链创新实践,呈现运载火箭发射、卫星智能制造、测控网络建设、数据融合应用等领域的前沿进展。

东方红航天生物携多项创新实践成果亮相航天科普展,源于空间诱变的农作物种子、微生物菌种,以及基于航天医学理念和健康监测的数智化主动健康管理系统吸引了中外来宾、专家学者和大量参观者驻足观看。
从深空探测的硬核突破,到民生普惠的技术转化,2026年中国航天日致敬中国航天七十载问天征途,也彰显航天科技服务人民、赋能民生的重要价值。让我们相聚在蓉城的春光里,看星辰大海的梦想照进神州大地,见证航天强国、航天惠民的壮阔图景徐徐展开。